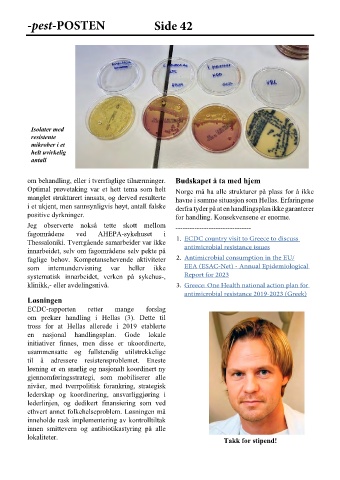

Page 42 - pesta2025_3
P. 42
-pest-POSTEN Side 42
Isolater med
resistente
mikrober i et
helt uvirkelig
antall
om behandling, eller i tverrfaglige tilnærminger. Budskapet å ta med hjem
Optimal prøvetaking var et hett tema som helt Norge må ha alle strukturer på plass for å ikke
manglet strukturert innsats, og derved resulterte havne i samme situasjon som Hellas. Erfaringene
i et ukjent, men sannsynligvis høyt, antall falske derfra tyder på at en handlingsplan ikke garanterer
positive dyrkninger. for handling. Konsekvensene er enorme.
Jeg observerte nokså tette skott mellom --------------------------------
fagområdene ved AHEPA-sykehuset i 1. ECDC country visit to Greece to discuss
Thessaloniki. Tverrgående samarbeider var ikke antimicrobial resistance issues
innarbeidet, selv om fagområdene selv pekte på
faglige behov. Kompetansehevende aktiviteter 2. Antimicrobial consumption in the EU/
som internundervisning var heller ikke EEA (ESAC-Net) - Annual Epidemiological
systematisk innarbeidet, verken på sykehus-, Report for 2023
klinikk,- eller avdelingsnivå. 3. Greece: One Health national action plan for
antimicrobial resistance 2019-2023 (Greek)
Løsningen
ECDC-rapporten retter mange forslag
om prekær handling i Hellas (3). Dette til
tross for at Hellas allerede i 2019 etablerte
en nasjonal handlingsplan. Gode lokale
initiativer finnes, men disse er ukoordinerte,
usammensatte og fullstendig utilstrekkelige
til å adressere resistensproblemet. Eneste
løsning er en snarlig og nasjonalt koordinert ny
gjennomføringsstrategi, som mobiliserer alle
nivåer, med tverrpolitisk forankring, strategisk
lederskap og koordinering, ansvarliggjøring i
lederlinjen, og dedikert finansiering som ved
ethvert annet folkehelseproblem. Løsningen må
inneholde rask implementering av kontrolltiltak
innen smittevern og antibiotikastyring på alle
lokaliteter. Takk for stipend!